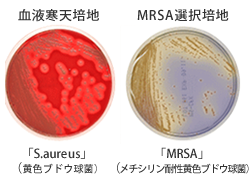

臨床検査部
業務内容
臨床検査室では、生理機能検査業務と検体検査業務を行っています。
生理機能検査業務は、患者様と直接接して行う検査が中心となります。循環生理検査、呼吸生理検査、神経生理検査、超音波検査など多くの生体検査業務を担っています。
検体検査業務は、患者様から採取した血液、尿、糞便、体腔液(胸水・腹水・心嚢液等)、分泌物などを、光学顕微鏡や自動分析装置などを用いて分析し、検査結果を報告します。
一般検査、血液検査、生化学検査、免疫血清検査、輸血検査(血液製剤管理を含む)、微生物検査があります。
採血室(検査に必要な血液を採取します)
検査項目により採血管が異なるため、検査内容を確認し必要な採血管を準備して採血を行います。
検体検査の窓口となる部門であるため、取り違えなどを防止するために患者様ごとにバーコードラベルを発番して検査過誤の防止に取り組んでいます。
痛みを伴う採血への患者様の負担軽減するための技術の向上や患者様への接遇の向上に努めています。

検体検査(患者様から採取した血液や尿などを検査します)
一般検査
尿、便、体腔液などの基本的な性状を調べます。

<主な検査内容>
- 尿定性検査(蛋白・糖・潜血など)
- 尿沈渣
- 便潜血反応
- 髄液検査
- 穿刺液検査(腹水・胸水・関節液・心嚢液)
- 尿中肺炎球菌
- 尿中レジオネラ
- 妊娠反応
血液検査
血液中の赤血球数・白血球数・血小板数などの 測定を行い、貧血や出血傾向、感染の有無などの病態把握をします。
また、血液中に白血病細胞や癌細胞などの異常細胞が出現していないかを顕微鏡下で観察します。
血液の固まりやすさを調べる検査などを行っています。

<主な検査内容>
- 血算
- 血液像
- 骨髄像
- 凝固系検査
生化学検査
生化学検査室では、患者様から採取した血液や尿、穿刺液などを専用の分析装置で分析し、依頼項目の測定を行います。肝機能、腎機能、脂質、血糖
<主な検査内容>
- 感染症、腫瘍マーカーなど

多くの検査結果を迅速に、かつ正確に提供できるよう努力しています。
輸血検査
重度の貧血、大量出血、手術時の出血、血液の凝固異常などの場合に輸血を行います。
厚生労働省の「輸血療法の実施に関する指針」に従い、輸血を安全に行えるよう、以下の検査や自己血の採取・保存を実施しています。
- 血液型検査
ABO式、Rh式血液型など - 不規則性抗体検査
ABO式血液型以外の赤血球に対する抗体の検査 - 交差適合検査
輸血用血液と患者様の血液の間で輸血適応かの確認 - 自己血輸血
患者様自身の血液を手術前に採血して保存しておき、手術の際に自分の血液を使用します。(輸血による感染症のリスクなどが低くなります)


微生物検査
微生物検査では、感染症を疑われた患者様から採取した検体に起炎菌(炎症を起こしている原因菌)が存在しているかどうかを調べます。
起炎菌を認めた場合、有効な抗生物質を特定するため、追加の検査を行います。
<主な検査内容>
- 塗抹検査
- 培養同定検査
- 薬剤感受性検査
- 迅速検査(ウイルス抗原・抗体検査)
感染対策
ICT活動:毎週1回、院内ラウンドに参加して耐性菌や分離菌の感受性などの情報をご提供しています。